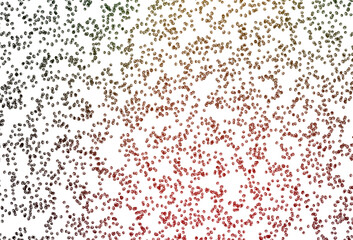
Obraz premium Light Green, Red vector cover with spots.

RABAT DO 40% - wygasa 19.04 !!! | Darmowa dostawa od 290zł | Potrzebujesz pomocy? Zadzwoń 22 678 07 67
(0)
Produkt dodany poprawnie do Twojego koszyka
Ilość
Razem
Ilość produktów w Twoim koszyku: 0. Jest 1 produkt w Twoim koszyku.
Razem produkty:
Dostawa: Do ustalenia
Razem
Kontynuuj zakupy Przejdź do realizacji zamówienia
Start > Obraz premium
Jakiego obrazu szukasz?
Użyj wyszukiwarki i szukaj wśród milionów zdjęć.
Obrazy Obraz premium
- #1690943665
- #112845863
- #401851310
- #1889792164
- #1926209450
- #1918239502
- #1245684357